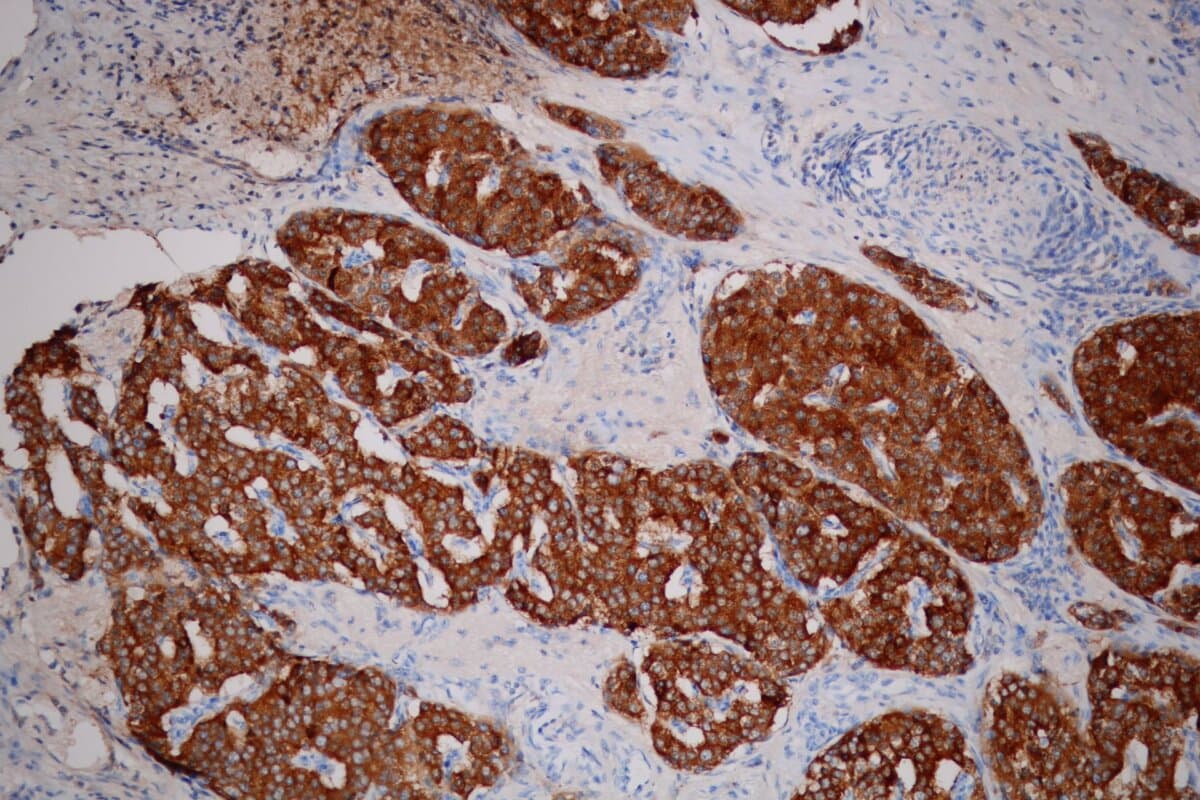

Der «Tsunami» der kleinen neuroendokrinen Tumoren
Irrelevanter Zufallsbefund oder «richtiger» Krebs? Experten legten dar, wie trotz unsicherer Evidenz zu kleinen GEP-NET gute Medizin gelingt. Und für das Pankreas zeichnete sich sogar ein neuer Vorhersagemarker ab.
Je besser der Zugang zu bildgebenden Verfahren und deren Qualität werden, desto mehr Neoplasien mit einem Durchmesser ≤ 2 cm werden im Bereich der endokrinen und neuroendokrinen Tumoren (NET) erkannt.
Anstieg der kleinen pankreatischen NET
Den Anstieg in der Inzidenz speziell dieser kleinen NET thematisierten zwei Referenten in einer genau dieser Problematik gewidmeten Session. Als «Tsunami» der kleinen pankreatischen NET (panNET) bezeichnete Professor Dr. Massimo Falconi, IRCCS Ospedale San Raffaele in Mailand, diese Entwicklung gar (1).
Auch für die grösseren panNET sei zwar ein Anstieg der Fallzahlen zu verzeichnen. Für die kleinen Läsionen liege der jährliche prozentuale Zuwachs mit 12,8 gegenüber 7,5 Prozent jedoch noch einmal signifikant höher, betonte er.
Nicht selten handele es sich dabei um Zufallsbefunde, die im Leben der Betroffenen nie klinisch relevant würden. Das mache es schwer, die richtige Balance zwischen Über- und Unterbehandlung zu finden. Glücklicherweise sei retrospektiven Erhebungen zufolge der Anteil an Überbehandlungen im letzten Jahrzehnt gesunken. Allerdings berichtete Professor Dr. José Díaz Tasende vom Universitätskrankenhaus 12 de Octubre in Madrid, er habe kürzlich einem jungen Mann ohne Beschwerden gegenübergesessen – mit fortgeschrittenem, hoch aggressivem neuroendokrinem Karzinom (NEC) und düsterer Prognose (2).
- Falconi M. ESMO Congress 2024; Vortrag «Pancreatic NEN: Watchful wait vs. radical surgery».
- Díaz Tasende J. ESMO Congress 2024; Vortrag «Gastric NEN: When to recommend radical surgery?».
- van Dijkum EN. ESMO Congress 2024; Vortrag «Appendiceal NEN: When to recommend radical surgery?».